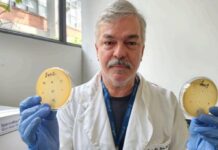
Pesquisa no Brasil descobre 62 novos vírus que matam bactérias

ANS decreta liquidação extrajudicial da Golden Cross; entenda
Decisão se deu depois de serem identificadas “anormalidades econômico-financeiras e administrativas graves” na operadora de saúde
A ANS (Agência Nacional de Saúde Suplementar) decretou liquidação...
Anvisa proíbe bala de tadalafila “Metbala”
Produto da FB Manipulação não tem autorização para ser fabricado ou vendido; o uso do remédio exige prescrição médica
A Anvisa (Agência Nacional de Vigilância...
Prefeitura de Dourados inicia emissão de carteirinhas para pessoas com fibromialgia
A entrega das primeiras carteirinhas acontecerá nesta terça-feira (13), durante solenidade na Câmara Municipal, e marcará também o lançamento do sistema online para solicitação...
Pesquisa no Brasil descobre 62 novos vírus que matam bactérias
Descoberta foi feita por pesquisadores da Unifesp, USP e Cetesb; vírus podem ajudar no combate a bactérias resistentes a antibióticos
Uma pesquisa conduzida por 3...
Saúde realiza Dia D de vacinação contra a gripe neste sábado
Meta é vacinar 90% do público-alvo de 81,6 milhões de pessoas Unidades básicas de saúde (UBS) e pontos de vacinação de todo o país promovem...
Tratar câncer em estágio avançado custa até 500% mais
Prevenção e diagnóstico precoce podem impactar a redução dos custos, a diminuição da incidência da doença e o aumento da chance de cura
O câncer...
Perda auditiva acelera declínio cognitivo, diz estudo
Pesquisa da USP analisou mais de 800 adultos e identificou impacto da audição na função cerebral
A perda auditiva em adultos, especialmente entre idosos, está...
São Paulo adota WhatsApp para confirmação de consultas médicas
Novo sistema envia mensagens com informações sobre agendamentos e opções para confirmar ou cancelar procedimentos
A Prefeitura de São Paulo, por meio da SMS (Secretaria...
Padilha usa músicas de Lady Gaga para divulgar vacina
Ministro da Saúde compartilhou que quem usa PrEP também poderá se imunizar contra hepatite A gratuitamente
O ministro Alexandre Padilha (Saúde) publicou em seu perfil...
Florianópolis decreta emergência por alta de doenças respiratórias
Florianópolis decreta emergência por alta de doenças respiratórias
Florianópolis decreta emergência por alta de doenças respiratórias